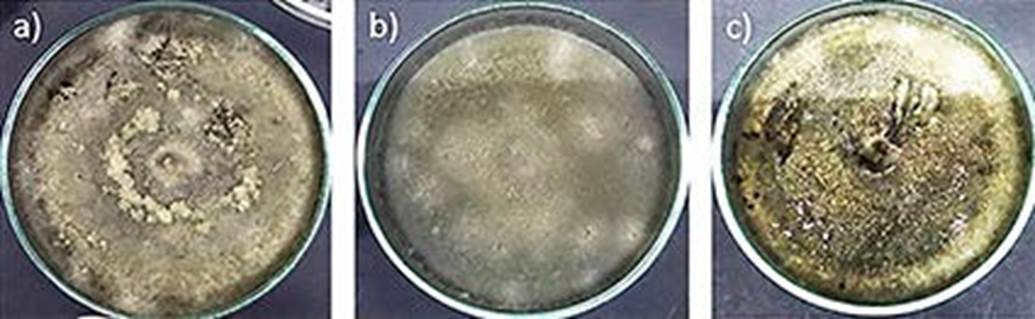

Introducción
El agave, conocido como maguey es endémico de Latinoamérica y Estados Unidos de Norteamérica, perteneciente a la familia de Agavaceae donde cuenta con nueve géneros y 340 especies (Reynoso et al. 2012). Su distribución en México es asimétrica debido a que se desarrollan mejor en los climas áridos y semiáridos, por lo que son abundantes en la Sierra Madre Occidental y Oriental, en el Altiplano mexicano y la península de Baja California (García et al. 2010, Pérez et al. 2016). En el estado de Hidalgo, México, las principales zonas magueyeras en las que se encuentra Agave salmiana son: Singuilucan, Epazoyucan, Zempoala, Cardonal, Ixmiquilpan, Arenal, Actopan, San Agustin Tlaxiaca, Apan, Tepeapulco y el Valle de Mezquital, la cual se aprovecha en la obtención de aguamiel, pulque, penca, mixiote y obtención de gusanos de maguey. Siendo Hidalgo uno de los estados donde hay una gran producción de pulque contando con 194 mil 579 toneladas, representando el 78.14 % de la producción nacional (Álvarez Duarte et al. 2018). Las agavaceas se han utilizado para cubrir necesidades básicas como alimento, fibras, forrajes, medicamentos y de construcción, además este tipo de planta es primordialmente utilizada para la elaboración de bebidas alcohólicas (Angeles Vázquez et al. 2017).
En los últimos años el cultivo del maguey se ha visto afectado por enfermedades ocasionadas por hongos patógenos y plagas, causando daños severos a nivel cultivo, producción y económico; por lo que la planta no puede ser utilizada y se recurre a su eliminación (SENASICA 2017). Las principales plagas y enfermedades son el picudo del agave, el escarabajo rinoceronte, la marchitez marginal, la pudrición del cogollo y la viruela o negrilla (CESAVEG 2008).
La viruela o negrilla es una enfermedad presente en las pencas de las plantas de Agave, en la cual se observan manchas foliares de color negro parecidas al hollín. Reportes indican que el posible daño es causado por un hongo llamado Asterina mexicana. Usualmente afecta a las pencas inferiores y cuando la enfermedad es más avanzada llega a necrosar la penca (Pérez et al. 2017). Asterina mexicana es un hongo patógeno perteneciente a la familia Microtiriaceae del orden de hongos Microtiriales, aunque de igual forma se relaciona dentro de los Discomicetos por la falta de dehiscencia (el cual es un sistema de abertura natural del pericarpio) y del epitecio (formación constituida por una masa amorfa, que puede recubrir la parte apical de las ascas y los parafisos) (Ohm et al. 2010). Sin embargo, se desconoce si es el único hongo causante de la enfermedad o si existen otros hongos.
Por lo anterior, en este trabajo, se colectaron hojas de A. salmiana en las regiones del San José el Salto, Epazoyucan, Chilcuaultla, el Cardonal y Zempoala del estado de Hidalgo, con la finalidad de identificar por métodos microbiológicos y moleculares, el agente causal de viruela o negrilla en plantas de Agave salmiana.
Materiales y métodos
Muestreo
Se realizó un muestreo de 10 plantas de Agave salmiana para cada una de las regiones Epazoyucan, Zempoala Chilcuaultla, San José el Salto y el Cardonal en el Estado de Hidalgo, colectando 3 hojas por planta con presencia de viruela o negrilla, durante los meses de enero a marzo 2018. El material vegetal fue trasladado y almacenado en el laboratorio a temperatura ambiente, hasta su procesamiento.
Recolección y obtención de esporas
Para la recolección de esporas se utilizó un bisturí estéril y se raspó sobre la cutícula de la hoja, las esporas se almacenaron en tubos eppendorf estériles para su posterior utilización. Antes de realizar el aislamiento y purificación, se realizó un frotis simple, poniendo una gota de agua sobre un portaobjetos y con un asa estéril se tomaron esporas, finalmente se observó a 40x en un microscopio óptico para conocer su morfología y características de la espora.
Aislamiento y purificación
Una vez que se recolectaron las esporas, se prepararon placas con agar papa dextrosa (PDA) el cual se esterilizó a 120 °C por 15 min. Las esporas fueron inoculadas por picadura en el centro de una caja petri, utilizando un asa bacteriológica recta estéril. Este procedimiento se realizó con cada una de las muestras recolectadas de las cinco regiones en estudio. Finalmente, todas las cajas se incubaron a 28 °C por siete días. De las cepas aisladas se realizaron resiembras para lograr la purificación, siguiendo la metodología anteriormente descrita.
Caracterización macroscópica y microscópica
De las cepas puras se determinó la morfología al describiendo su forma, apariencia, color, tamaño y consistencia del micelio. Para la caracterización microscópica del hongo se realizó un microcultivo incubando en cámara húmeda a 28 °C durante una semana. Pasado ese tiempo se tomaron tanto el cubre como el portaobjetos eliminado el agar, cuidando de no dañar las estructuras fúngicas desarrolladas y se montaron para su observación en un microscopio a un aumento de 40x, tiñendo las muestras con lactofenol y azul de algodón (Arias Cifuentes y Piñeros Espinosa 2008).
Identificación molecular de los aislados
Para la identificación molecular se analizaron los resultados de microoscopia y derivado que todas las cepas presentaban la misma morfología macro y micro, se seleccionó la cepa aislada de la región de Epazoyucan, de la cual se realizó la extracción de ADN por el método descrito por Weising et al. (2005).
El ADN obtenido fue utilizado como molde para la amplificación del espaciador interno ITS de la región del ADN ribosomal del gen ARNr 18S, mediante PCR en un termociclador SimpliAmp Thermal Cycler utilizando los iniciadores universales ITS1 (5´TCCGTAGGTGAACCTGCGG3´) e ITS4 (5´TCCTCCGCTTATTGATAT-GC3´) (White et al. 1990).
Con la finalidad de conocer la integridad del DNA y de los productos de la PCR se realizó una electroforesis en gel de agarosa 1 % (p/v) disuelto en buffer TAE 1X (Tris-Acetato 40 mM, EDTA 2 mM, pH 8). El gel se corrió a 80 V durante 45 min y se tiñó con bromuro de etidio (10 mg/mL) en TAE durante 15 min, posteriormente se observó a través de un fotodocumentador con luz ultravioleta. El tamaño de las moléculas de DNA se determinó comparando la distancia de migración con las correspondientes a un marcador de 100 pb.
La purificación de los productos de amplificación se hizo siguiendo el protocolo descrito a continuación: a cada muestra de PCR se le añadieron 100 µL de isopropanol, y se incubaron en hielo durante 25 min. Posteriormente se centrifugaron a 12 500 rpm por 15 min a 4 °C. Se descartó el sobrenadante y al precipitado se le añadieron 100 µL de etanol al 70 % frío y se incubaron en hielo durante 25 min. Las muestras se volvieron a centrifugar a 12 500 rpm por 15 min a 4 °C, se decantaron y dejaron secar. El precipitado fue resuspendido en 25 µL de agua inyectable.
Las muestras purificadas se enviaron a la Unidad de Síntesis y Secuenciación de ADN (USSDNA) del Instituto de Biotecnología de la Universidad Nacional Autónoma de México. Los electroferogramas obtenidos fueron transformados a secuencias de nucleótidos en formato de texto, los cuales fueron visualizados y editados de forma manual utilizando el software Chromas lite (https://technelysium.com.au/wp/chromas/) y BioEdit v. 7.2.6 (https://bioedit.software.informer.com/7.2/). Las secuencias editadas obtenidas se compararon mediante el uso del algoritmo del programa BLAST en la base de datos del GenBank del National Center for Biotechnology Information (NCBI).
Resultados y discusión
El material vegetal colectado de A. salmiana de las regiones en estudio, presentaban características de la enfermedad viruela o negrilla en Agave (Figura 1). Aunque la información de esta afección es muy limitada, se tienen reportes que el posible agente causal es A. mexicana (Civantos 1999), un hongo ascomiceto que ataca sobre todo a las pencas bajas llegando a necrosarlas. Su diseminación puede ser el viento, agua y organismos pequeños como insectos que actúan como vectores (CESAVEG 2008, Lastres y Soza, 2009). Al ser un hongo biotrófico crece de manera directa en los tejidos de las plantas, las cuales se manifiestan como manchas en toda la hoja o parte de ella (Guatimosim et al. 2015). Hofmann y Piepenbring (2011), mencionan que los hongos pertenecientes a la familia Asterinaceae crecen en los tallos u hojas verdes de las plantas.
Las esporas obtenidas de las lesiones al ser observadas en microscopio óptico, muestran similitud en su estructura, presentando la pared del ascomato superficial pigmentada de un marrón oscuro, además de triotecio (Figura 2), estas características son similares a Asterinales (Hongsanan et al. 2014).
De las esporas se obtuvieron los micelios (50 cepas en total), los cuales presentaron estructuras filamentosas, algodonosas de forma aérea, con pigmentación negruzca en medio PDA (Figura 3), de acuerdo a Meena et al. (2017) estas características son similares a la familia Asterinaceae, que posiblemente pudiera ser A. mexicana. Sin embargo, hay una gran variedad de hongos que presentan estas características (Anke y Weber 2009). De las observaciones microscópicas se identificó un micelio hialino septado y conidióforos pardos, con conidios curvos en forma de elipse de color marrón con septos transversales. Por lo anterior, se puede descartar que los aislados correspondan A. mexicana, debido a que este fitopatógeno presenta un micelio tipo meliola, con un peritecio pequeño de color marrón que contiene esporas uniseptadas y constreñidas (Ellis y Everhart 1900). Con estos resultados se podría suponer que las cepas aisladas, corresponden al género Curvularia, debido a la morfología de los conidios de forma curva y septada. Este género podría estar asociado a la enfermedad de la negrilla en el maguey, debido a que el género Curvularia es considerado un fitopatógeno secundario, causando manchas foliares negras además de que está asociado al marchitamiento de plantas (Pérez et al. 2009). Curvularia lunata, se ha identificado principalmente en plantas de maíz (Zhang et al. 2019). Para descartar esta hipótesis, del total de cepas aisladas de las diferentes regiones y al compartir las mismas características, se seleccionó la cepa EZ01 pues compartía las mismas características coloniales y microscópicas con todas las demás.
El amplificado obtenido presentó un tamaño esperado de 500-600 pb. La literatura menciona que para la identificación molecular de C. lunata se realiza de las regiones internas transcritas ITS1 e ITS4 entre los genes ribosomales (rDNA) 18S-5.8S y 5.8S- 28S (Ríos et al. 2017). El fragmento de DNA de la cepa EZ01 fue secuenciado y se obtuvó la siguiente secuencia parcial: GTCGTAATATGAAGGCTGTACGCGGCTGTGCTCT-CGGGCCAGTTTTGCGGAGGCTGAATTATTTATTACCCTTGTCTTTTGCGCACTTGTTGTTTCCTGGGCGGGTTCGCCCGCCACCAGGACCACATCATAAACCTTTTTTATGCAGTTGCAATCAGCGTCAGTATAACAAATGTAAATCATTTACAACTTTCAACAACGGATCTCTTGGTTCTGGCATCGATGAAGAACGCAGCGAAAT-GCGATACGTAGTGTGAATTGCAGAATTCAGTGAATCATCGAATCTTTGAACGCACATTGCGCCCTTTGGTATTCCAAAGGGCATGCCTGTTCGAGCGTCATTTGTACCCTCAAGCTTTGCTTGGTGTTGGGCGTTTTTT-GTCTTTGGTTGCCAAAGACTCGCCTTAAAAGGATTGGCAGCCGGCCTACTGGTTTCGCAGCGCAGCACATTTTTGCGCTTGCAATCAGCAAAAGAGGACGGCAATCCATCAAGACTCCTTCTCACGTTTGACCTCGGATCAGGTAGGGATACCCGCTGAACTTAAGCATATCAATAAGCGGAGAA.
Figura 2 Morfología micelial de hongos aislados a partir de lesiones de viruela o negrilla en hojas de A. salmiana: a) cepa DS01 aislada de San José el Salto, b) cepa EZ01 aislada de Epazoyucan y, c) cepa CH01 aislada de Chilcuaultla, Hidalgo.

Figura 3 Morfología microscópica de hongos aislados a partir de lesiones de viruela o negrilla en hojas de A. salmiana: a) cepa DS01 aislada de San José el Salto, b) cepa EZ01 aislada de Epazoyucan, c) cepa CH01 aislada de Chilcuaultla, d) cepa CD01 aislada del Cardonal y, e) cepa ZP01 aislada de Zempoala, Hidalgo.
Al realizar el análisis BLAST de la secuencia obtenida se encontró un 100 % de similitud con Curvularia lunata. El cual es un patógeno facultativo en plantas y suelos, ocasionando daños en las hojas, flores, semillas y tallos, que van desde manchas foliares pequeñas hasta lesiones de mayor tamaño (Estrada y Sandoval 2004).
Este hongo es responsable de varias enfermedades en las plantas, especialmente a las que pertenecen a la familia Poaceae, pero en la actualidad con los cambios ecológicos, los efectos que produce dicho hongo se ven en otras plantas, como en este caso el maguey, ya que prevalece en ambientes húmedos y cálidos, además de causar daños a los cultivos de manera significativa, impidiendo la fotosíntesis adecuada, provocando pérdida en la producción agrícola (Garcés et al. 2011, Resplandes et al. 2018). Sin embargo, se le ha relacionado principalmente como el agente causal de la mancha foliar en maíz (Zhang et al. 2019).
Los resultados obtenidos en esta investigación son el primer reporte sobre el aislamiento e identificación de C. lunata en un hospedero atípico como lo es A. salmiana y con posible asociación a la enfermedad de viruela o negrilla. Reportes han demostrado que C. lunata ataca a piñón (Jatropha curcas), ocasionando manchas foliares en hojas basales (Cisneros-López et al. 2012); en cacao (Theobroma cacao) (Cuervo-Parra et al. 2017), chile habanero (Capsicum chinense Jacq.) vara de San José (Polianthes tuberosa L.) y piñón (Pinus pinea L.) (Cristóbal-Alejo et al. 2012). Por otro lado, en otro estudio se identificó a C. lunata en Aloe vera, presentando síntomas con lesiones circulares en la punta y la superficie abaxial de las hojas. Las lesiones fueron de color rojo claro bordeado por tejidos empapados de agua. A medida que avanzó la enfermedad, las lesiones fueron hundidas, de color granate. En etapas posteriores, las lesiones se secaron y se volvieron de color marrón oscuro (Avasthi 2015).
Las características microscópicas de C. lunata indican que el hongo presenta hifas vegetativas tabicadas, ramificadas, subhialinas a pardas, lisas a asperuladas. Con presencia de conidioforos (39-430 μm de largo, 4-9 μm de ancho en la base y 2.5-6 μm de ancho hacia el centro) septados, simples o ramificados, a menudo con una base bulbosa y geniculados o doblados en el ápice, de color marrón claro a oscuro, con paredes celulares más gruesas que las de las hifas vegetativas. Células conidiógenas (4-20 por 3-13 μm) terminales e intercalares, subcilíndricas y subglobosas o de forma irregular. Conidios casi siempre de cuatro celdas, lisos a asperulados, a menudo curvados en la tercera celda desde la base, que es más grande que las otras, células intermedias de color marrón. La colonia es funiculosa a algodonosa, negra olivácea, con un margen fimbriado; reverso negro. Las colonias son algodonosas y grises en el centro, negruzcas y aterciopeladas hacia la periferia, con un margen fimbriado; marrón inverso en el centro, color crema hacia la periferia (Manamgoda et al. 2012). Dichas características corresponden a lo observado en el presente estudio.
Conclusiones
Dentro del análisis, las cepas que se aislaron de las lesiones de viruela o negrilla en hojas de A. salmiana mostraron características macroscópicas y microscópicas correspondientes al género Curvularia y la identificación molecular corroboró la presencia de Curvularia lunata. De lo anterior se deduce que la enfermedad de viruela o negrilla presente en A. salmiana no necesariamente puede ser causada por A. mexicana y que esta puede estar asociada con C. lunata, siendo el primer reporte donde se aísla el fitopatógeno de un hospedero atípico como A. salmiana. Es necesario realizar más estudios sobre el comportamiento del hongo y establecer la relación con la enfermedad durante el proceso de infección. Así como, buscar métodos de control biológico que permitan disminuir o erradicar la enfermedad en agaves y con esto ayudar al buen desarrollo de la planta y aumentar su aprovechamiento.










nova página do texto(beta)




